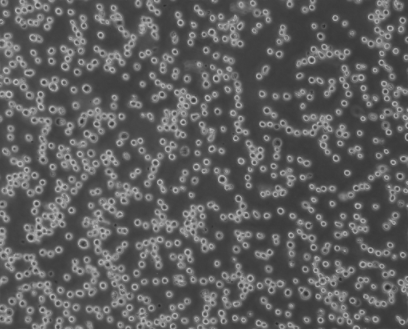
新闻图片2

武汉尚恩生物技术有限公司品牌商
6 年
手机商铺
商家活跃:
产品热度:
- NaN
- 0.2999999999999998
- 0.2999999999999998
- 2.3
- 2.3
重组人粒细胞-巨噬细胞刺激因子rhGM-CSF
¥750
推荐产品
公司新闻/正文
细胞攻略 | THP-1(人单核细胞白血病细胞)细胞培养教程
1886 人阅读发布时间:2023-07-24 09:40
细 胞 基 本 信 息

▲细胞正常生长形态照片
细胞名称:THP-1(人单核细胞白血病细胞)
细胞别称:THP1; THP 1; THPI; THP-1(ATCC); Tohoku Hospital Pediatrics-1
细胞货号: SNL-044
生长特性: 悬浮
培养条件: 1640+10%FBS+0.05mM β-mercaptoethanol+1% P/S
培养环境: 空气,95%;二氧化碳 (CO2),5%
细胞简介:THP-1细胞从一名1岁的患有急性单核细胞性白血病的男孩的外周血中分离建立,细胞可以吞噬乳胶颗粒和激活的红细胞,细胞膜和胞浆内均没有免疫球蛋白,表达C3R和FcR。THP-1细胞可受佛波酯、TPA诱导向单核系方向分化。THP-1细胞可以用于3D细胞培养、免疫系统紊乱、免疫学和毒理学研究,也是一种合适的转染宿主。
THP-1细胞培养注意事项
THP-1细胞悬浮圆形生长,偶有小聚团,属于正常现象,无需吹散;
圆形透亮、细胞膜完整的细胞是活细胞,如果无法判断,可以取少量细胞用台盼蓝染色后计数确定细胞活率;
少量细胞附着瓶底属于正常现象,可将悬浮细胞转移至新瓶,丢弃贴壁的细胞;
THP-1喜欢偏酸环境,培养基呈橘色时可不用换液,补充适量新鲜培养基维持一天再进行换液或传代操作;
THP-1有密度依赖性,密度低时生长较慢,培养密度维持在30万-100万细胞/mL之间为宜,超过80万细胞/mL即可传代;
THP-1复苏后恢复较慢,如无特殊情况,复苏后48小时内不对细胞进行操作;
THP-1生长需要稳定的环境,不频繁拿出培养箱,不频繁离心;
培养时瓶子竖立放置(瓶盖朝上),可增加细胞局部密度,促进细胞增殖。
β-巯基乙醇可以消除活性氧自由基,维持细胞高密度生长。若培养基中不添加β-巯基乙醇,长期培养细胞可能会出现大量贴壁,严重聚团等情况。
THP-1 细 胞 换 液 方 法
离心换液法:
1. 准备所需的培养基、离心管以及无菌枪头等;(培养基提前预热)
2. 将所有细胞悬液转移至离心管中;
3. 900-1000rpm,3min离心;
4. 弃上清,加5mL PBS轻轻重悬细胞进行润洗,再900-1000rpm,3min离心;
Tips:此处PBS润洗是为了去除细胞碎片,平时培养若细胞碎片不多可以忽略此步骤,若碎片偏多,可以重复润洗2次。
5. 培养瓶中加入适量新鲜培养基;
6. 离心完成后弃上清,加适量新鲜培养基轻轻重悬细胞沉淀,将细胞悬液接种回培养瓶中,混匀细胞,放入培养箱中继续培养。
半换液法:
1. 准备所需的培养基、离心管以及无菌枪头等;(培养基提前预热)
2. 将培养瓶竖立静置一段时间,待细胞沉底;(肉眼观察细胞沉底情况)
3. 小心吸出一半的培养基,转移到离心管;
4. 900-1000rpm 3min离心,离心管里若有细胞,则用新鲜培养基重悬后放回原瓶;
5. 原瓶补充一半的新鲜培养基。
Tips:半换液2-3次后需要进行离心换液。
THP-1 细 胞 传 代 方 法
离心法:
1. 取少量细胞悬液进行计数确定细胞密度,密度80万/mL以上传代,并根据计数结果确定传代比例;
2. 准备所需的培养基、离心管以及无菌枪头等;(培养基提前预热)
3. 用移液器吸取培养瓶内细胞悬液转移至离心管中;
4. 900-1000rpm,3min离心收集细胞;
5. 在培养瓶中加入适量新鲜培养基;(T25推荐10mL,T75推荐15mL)
6. 离心完成后,弃离心管内上清,然后加入适量新鲜培养基,轻轻重悬吹散细胞,将细胞悬液均匀接种至培养瓶中,轻轻混匀后将细胞放入培养箱中继续培养。
Tips:悬浮细胞通常都偏脆弱,注意控制吹打力度尽可能轻柔和离心转速以及时间不要过高,避免细胞受机械损伤。
直接分瓶法:
1. 取少量细胞悬液进行计数确定细胞密度,密度80w/mL以上传代,并根据计数结果确定传代比例;
2. 轻轻摇晃培养瓶,使细胞均匀分散;
3. 用移液器吸取培养瓶内细胞悬液,均分到若干个新培养瓶中,每瓶再补充适量的新鲜培养基,轻轻混匀后将细胞放入培养箱中继续培养。
Tips:用直接分瓶法传代1-2次后需进行离心传代。
THP-1 细 胞 冻 存 方 法
1. 取少量细胞悬液进行计数确认细胞密度。
Tips:若冻存前培养基已经变黄,先换液静置培养4h左右,待细胞活力稳定后再进行冻存。
2. 准备所需的培养基、PBS、血清、DMSO、离心管以及无菌枪头等;(试剂需提前预热)
3. 根据收集到细胞量,配制相应量的冻存液,并准备相应数量的冻存管,在冻存管上标志细胞名称,代次,冻存时间等信息。推荐冻存液配方:90%FBS+10%DMSO;冻存密度200-300万细胞/mL/管。
Tips:冻存密度过低将导致复苏后状态不佳。
4. 将细胞悬液转移至离心管中1000rpm,3min离心收集细胞;
5. 离心完成后弃上清,加入相应量的配置好的冻存液轻轻重悬混匀细胞,将细胞悬液分装至冻存管中。注意吹打力度,不要产生过多气泡;
Tips:加入冻存液混匀细胞后及时分装并将细胞降温冻存,以减少DMSO对细胞的毒性。
6. 将细胞放置程序降温冻存盒中,再将冻存盒转移至-80℃冰箱进行降温冻存。
7. 次日复苏一管检查冻存效果,确认没问题后及时将冻存细胞放置液氮中保存,细胞在-80℃冰箱放置时间不要超过3天。
THP-1 细 胞 复 苏 方 法
1. 提前将水浴锅预热至37℃,培养基复温至室温或37℃,离心机设置好转速;
2. 将冻存细胞从液氮或-80℃冰箱中取出,迅速置于37℃水浴,快速摇晃至完全融化,融化时间1min左右;
Tips:若液氮或冰箱距离细胞房较远,细胞需要放在干冰或冰盒上运送至细胞房。
3. 直接将冻存管900-1000rpm 2min离心,同时在培养瓶中加入适量新鲜培养基;
4. 离心完成后弃上清,吸取1mL新鲜培养基轻轻重悬细胞,吹散细胞后接种到培养瓶中;
5. 使用十字法或8字法将细胞混匀后置于培养箱中培养。
Tips:整个细胞复苏过程在尽可能5-10min内完成。
THP-1 细 胞 收 货 攻 略
1. 拆封包装盒,确认细胞,说明书等是否齐全,收货细胞名与所购买细胞是否符合;
2. 观察细胞培养瓶是否完好,有无漏液,培养瓶内培养基是否有肉眼可见的絮状物或者浑浊等,发现异常及时拍照联系销售人员;
3. 确认无异常后,将培养瓶表面消毒,然后撕掉封口膜竖立放入培养箱平衡4h左右,让悬浮细胞沉下培养瓶底部;
4. 平衡过程中可以仔细阅读细胞说明书,知悉细胞所需培养体系,培养环境以及培养注意事项等;
5. 平衡完成后竖立取出细胞培养瓶,此时大部分细胞沉在培养瓶底部,小心吸取上清至离心管中,保留10mL左右培养基在培养瓶内,小心操作,尽量不要吸到沉在底部的细胞;
6. 将离心管1200rpm,5min离心收集未沉下培养瓶底部的细胞,上清可以4℃保存,后续用于培养细胞,以平稳过度到自己的培养基。将收集到的细胞接种至原培养瓶;
7. 轻轻混匀细胞,取100-200ul细胞悬液进行计数,根据计数结果调整细胞培养密度。然后置于培养箱中培养。
若您有任何问题,欢迎在评论区给小尚留言哦!
产品推荐
【SNL-044】 THP-1(人单核细胞白血病细胞)
【SNLM-044】THP-1细胞专用完全培养基
END



